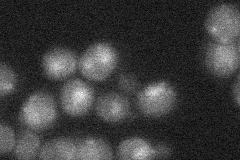
YNL025C
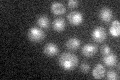
YNL025C

View description
Cyclin-like component of the RNA polymerase II holoenzyme, involved in phosphorylation of the RNA polymerase II C-terminal domain; involved in glucose repression and telomere maintenance
Localization:
Intensity:
Fold change:
Significance:
-
C’ GFP library in SD

nucleus19.52 -
N' NOP1pr-GFP in SD

cytosol,nucleus41.3061 -
N' TEF2pr-mCherry in SD

cell periphery,vacuole0 -
N' NATIVEpr-GFP in SD
nucleus22.0918 -
N' TEF2pr-VC and Cyto-VN in SD

#N/A0 -
C’ GFP library in SD+DTT

nucleus24.971.27No -
C’ GFP library in SD+H2O2

nucleus20.411.04No -
C’ GFP library in Starvation Media
nucleus231.17No -
C’ GFP library on the background of Pup2-DaMP

nucleus -
C’ GFP library on the background of CCT mutant

nucleus22.63831.15919No
